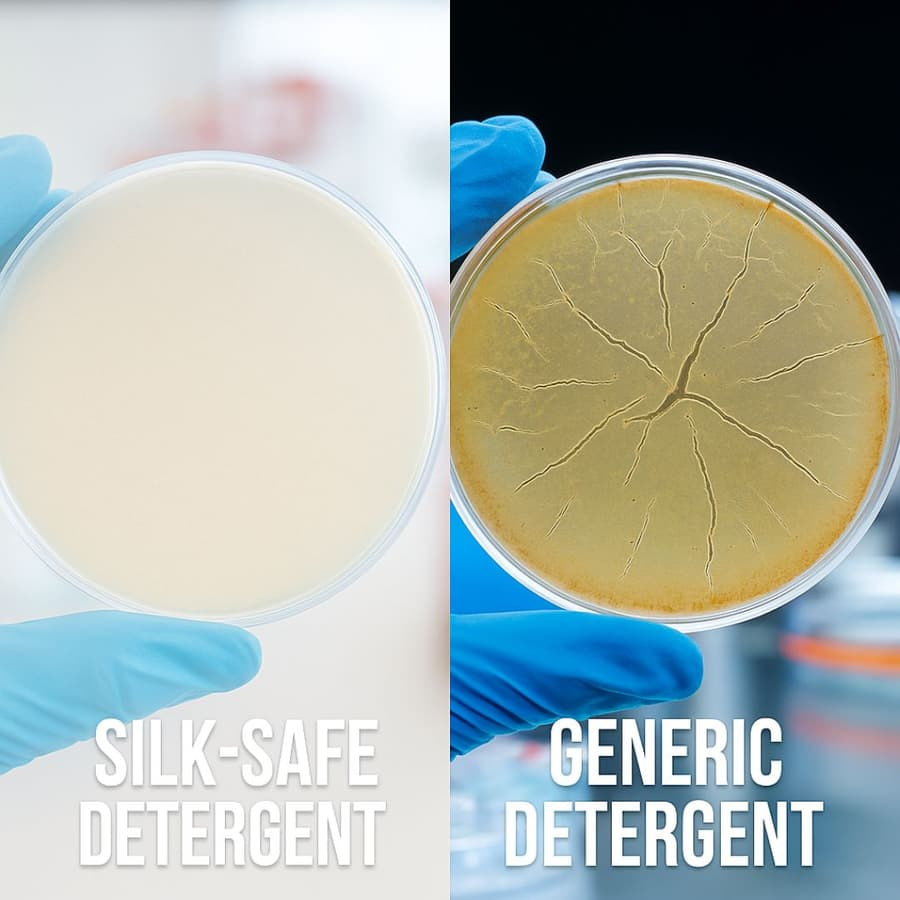

The Hidden Reason Your Expensive Silk Products Are Getting Ruined (And How One Simple Switch Can Save Them)

If you've invested in premium silk pillowcases, sheets, or clothing, you might be unknowingly destroying them every time you wash them. Here's what silk experts don't want you to know about regular detergent – and the game-changing solution that's saving thousands of dollars in silk replacements.